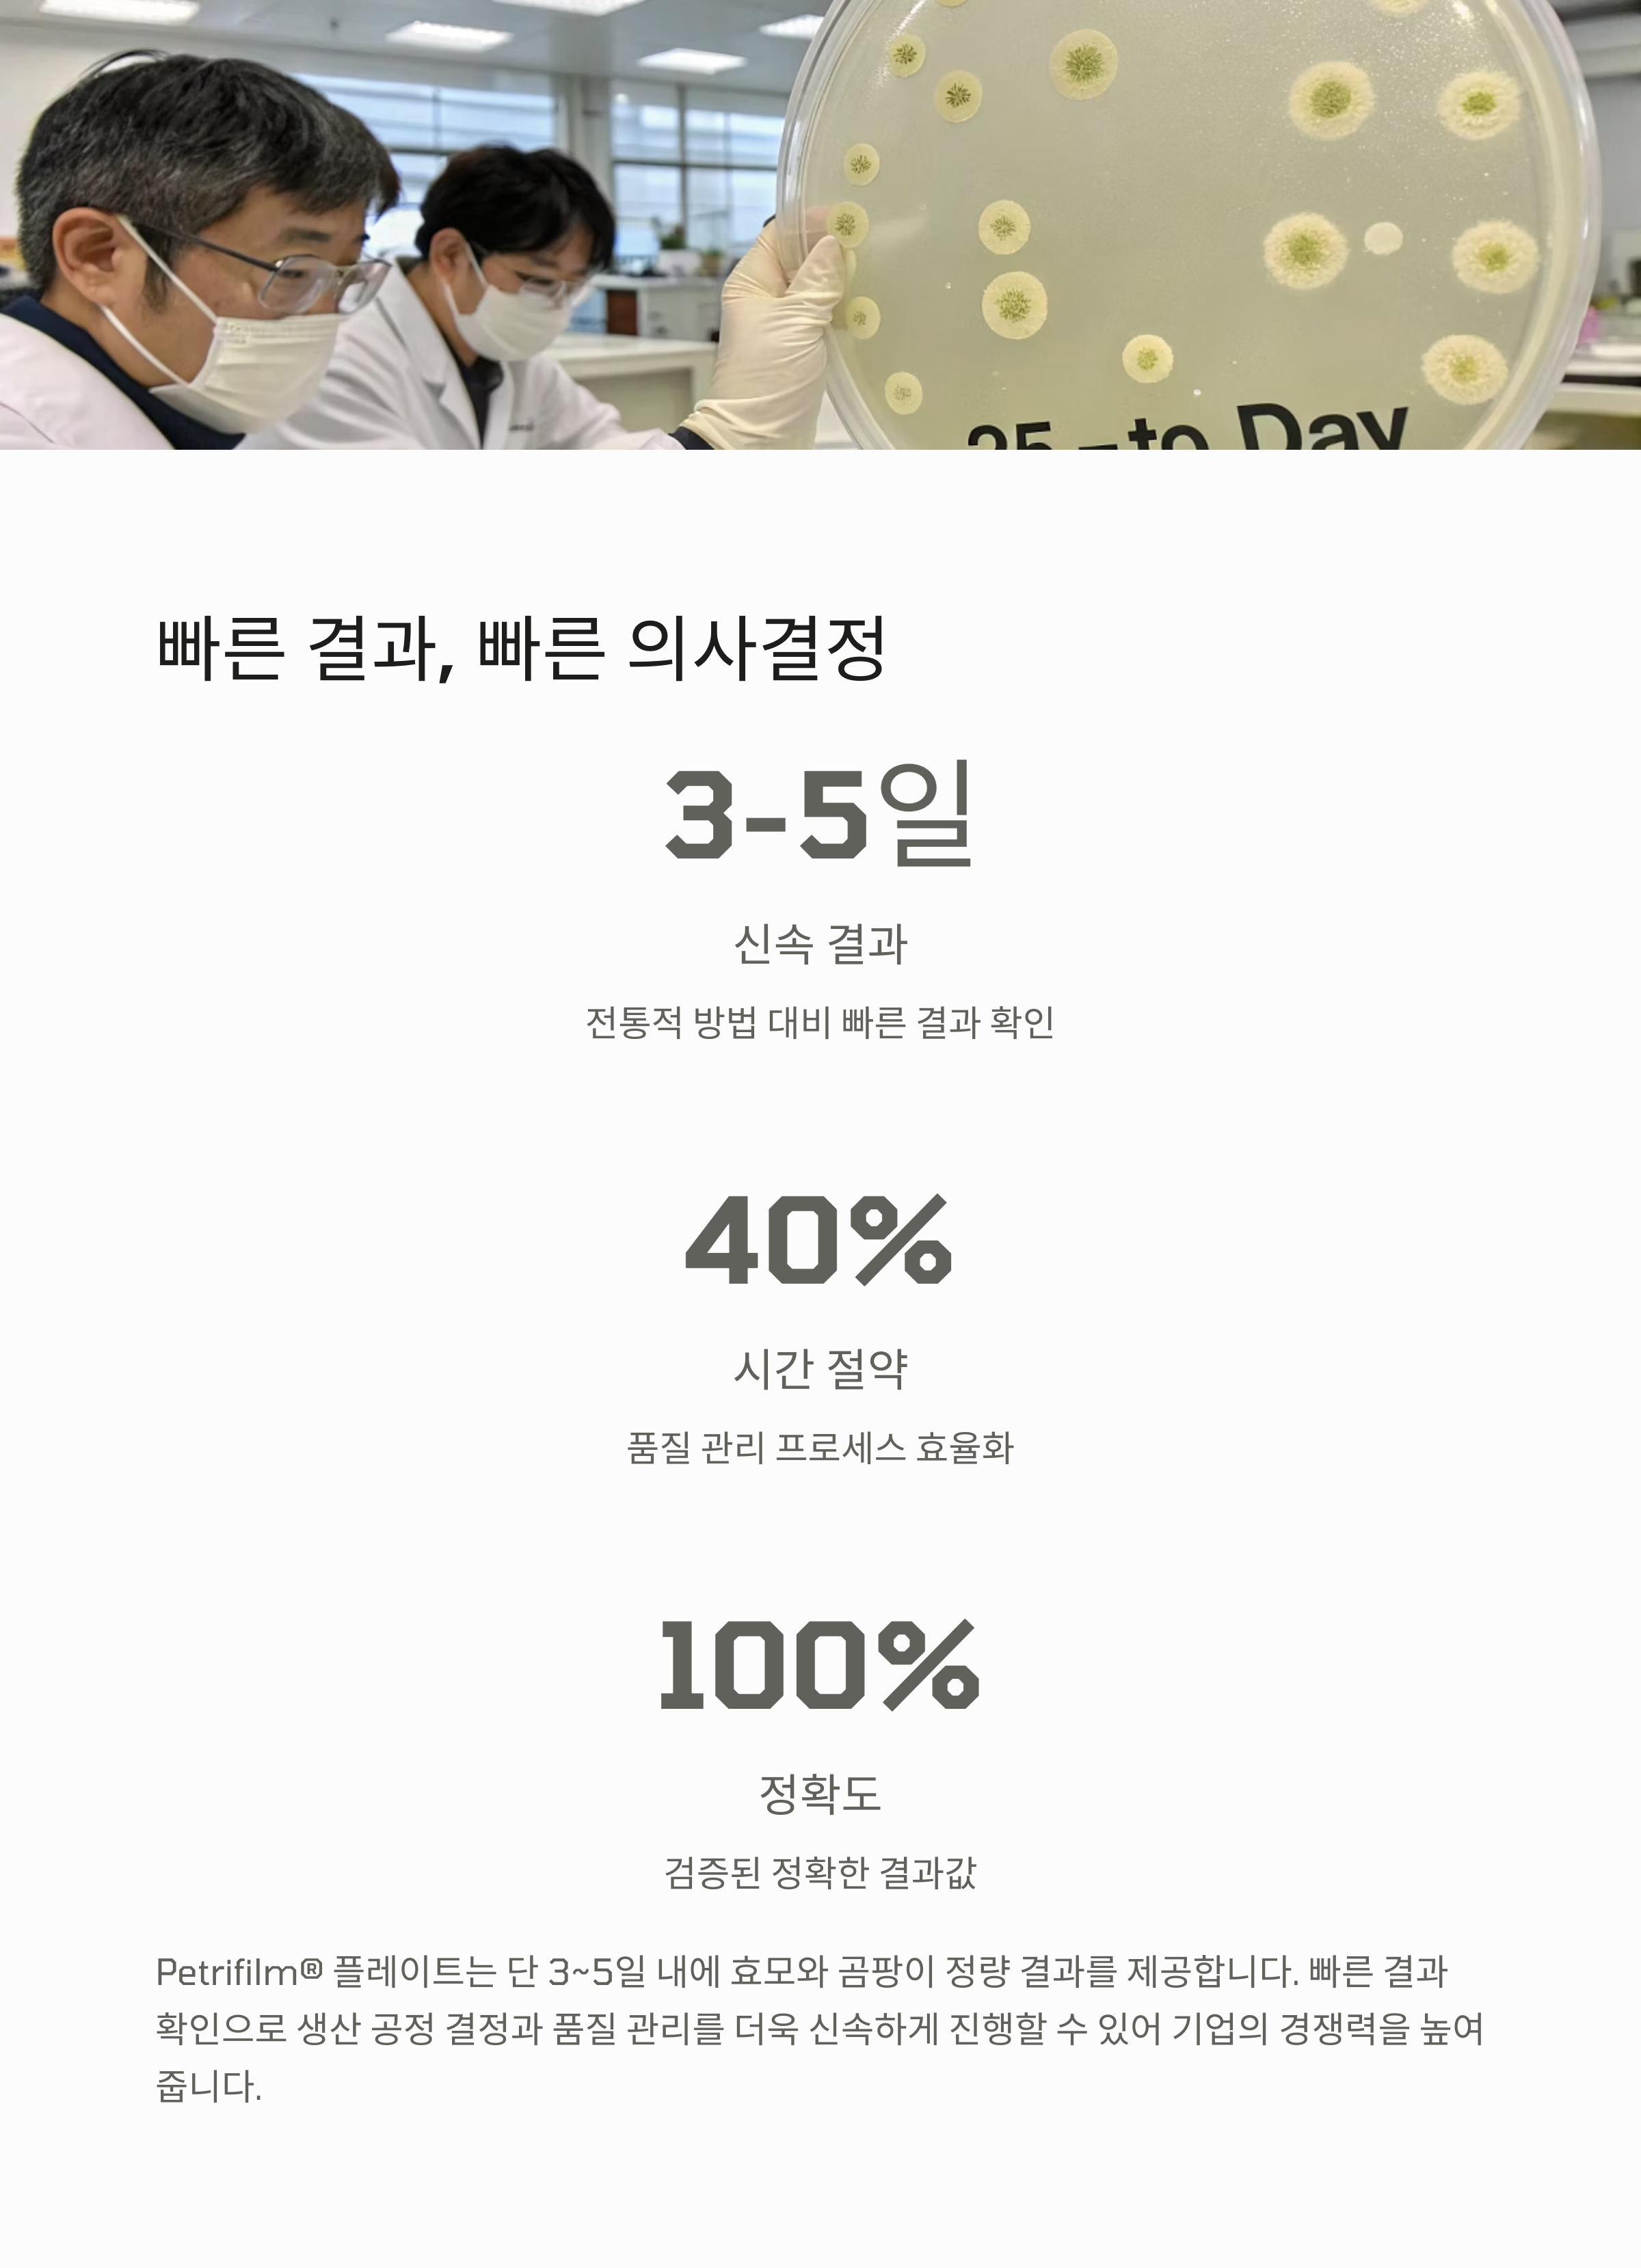
효모 곰팡이 분석법 비교 - 전통 배지와 Petrifilm의 분석 시간/결과 차이

📌 한눈에 보는 핵심 요약 카드
- 제품명 : Neogen Petrifilm® 효모 및 곰팡이 측정 플레이트
- 기능 : 효모·곰팡이 정량 검사 / 식품 및 음료 품질 관리에 최적
- 장점 : 샘플 준비만으로 간편 사용, 3~5일 내 결과 확인 가능
- 인증 : AOAC 공식 인증 (OMA #997.02) / 200건 이상 글로벌 검증
- 사용 분야 : 식품 공장, 병입수 업체, 외부 분석 기관 등
- WHY? : 정확성 + 속도 + 간편성, 미생물 분석의 새로운 기준!
왜 효모 및 곰팡이 측정이 중요한가?
식품과 음료 산업에서 가장 큰 위협 중 하나는 눈에 보이지 않는 미생물 오염입니다. 그중 효모와 곰팡이는 제품의 맛, 향, 안정성에 영향을 미치며, 심할 경우 리콜 사태로 이어질 수 있습니다. 특히 유통기한이 짧거나 민감한 제품군에서는 더욱 철저한 미생물 관리를 요구합니다.
이러한 현실 속에서 가장 많은 실무자들이 고민하는 부분은 👉 어떻게 효율적이고 정확하게 효모·곰팡이를 분석할 것인가입니다. 그 해답이 바로 Neogen의 Petrifilm® 플레이트입니다.
기존 분석법 vs. Petrifilm® 플레이트의 차이점
전통적인 미생물 분석은 복잡합니다. 배지를 준비하고, 멸균하고, 도포하고, 배양하고… 그 모든 과정은 시간도, 인력도 많이 소모합니다. 하지만 Petrifilm® Yeast and Mold Count Plate는 ✅ 샘플만 준비하면 바로 배양 가능 ✅ 3~5일 내 결과 도출 ✅ 시각적으로 효모와 곰팡이 구분 가능 이렇게 간단해집니다.
또한 플레이트에는 지시제 및 항생제, 젤화제가 포함되어 있어 한 장으로 완결형 분석이 가능합니다. 이 하나의 플레이트가 품질 관리의 속도와 정확성을 혁신적으로 바꿔주는 셈이죠.
신뢰성을 증명하는 AOAC 인증 & 글로벌 평가

이 제품은 단순한 실험 도구가 아닙니다. AOAC® OMA #997.02 공식 인증 제품이며, 전 세계 200건 이상의 평가·인증·논문에서 신뢰성을 입증받았습니다. 약 40년 동안 글로벌 식품안전 전문가들이 사용해 온 이 플레이트는 검증된 신뢰도와 일관된 정확성으로 현재도 수많은 기업과 실험실에서 핵심 도구로 사용되고 있습니다.
3M에서 Neogen으로, 글로벌 식품 안전 솔루션의 계승과 발전


기존에 Petrifilm® 제품군은 세계적인 과학 기술 기업 3M Food Safety Division을 통해 유통되었으며, 수십 년 동안 전 세계 식품 및 음료 산업 현장에서 널리 사용되어 왔습니다. 하지만 2022년, 3M의 식품 안전 부문이 Neogen Corporation에 인수되면서 Petrifilm® 제품의 제조 및 공식 공급처가 Neogen으로 변경되었습니다.
이번 브랜드 전환은 단순한 소유권 변경이 아닌, 식품 안전 기술의 통합과 고도화를 의미합니다.
Neogen은 전 세계적으로 미생물학, 진단 기술, 식품 품질관리 분야에서 강력한 전문성과 경험을 가진 기업으로, 이번 인수를 통해 Petrifilm® 제품의 신뢰성과 서비스 품질을 더욱 강화하고 있습니다.
- 기존 3M Petrifilm®과 동일한 제조 프로세스 및 품질 유지
- AOAC 인증과 글로벌 검증 데이터 그대로 승계
- Neogen만의 강화된 고객 지원 및 교육 서비스 제공
따라서 기존 사용자들은 별도의 변경 없이 동일한 방식으로 제품을 사용할 수 있으며,추가적으로 Neogen의 교육, 문서, 기술 지원 시스템을 통해 더욱 향상된 사용자 경험을 기대할 수 있습니다. 브랜드는 바뀌었지만, 제품의 신뢰성과 효과는 변함없습니다.
오히려 글로벌 수준의 품질관리 솔루션으로 더욱 강화된 형태로 시장에 제공되고 있는 것입니다.
하기 주소는 Neogen 제품 성적서 검색 주소 입니다.
https://www.neogen.com/ko/document-search/
효모 vs. 곰팡이 – 판독이 이렇게 쉬울 수 있다?
- ✔️ 효모: 작고 파란색·청록색의 군락, 가장자리가 명확함
- ✔️ 곰팡이: 크고 다양한 색상, 퍼지는 형태와 중심점 존재
이처럼 육안으로도 구분이 가능하여 분석자의 숙련도에 따른 오차를 줄일 수 있는 직관적 설계가 강점입니다.
사용 예시 – 실험실부터 대형 식품 공장까지
Petrifilm® 플레이트는 다음과 같은 곳에서 다양하게 사용됩니다:
- 🏭 식품 제조 현장: 생산 전·후 공정에서 오염 여부 확인
- 🚰 병입수 및 음료 제조사: 유통 전 안전성 검사
- 🔬 외부 분석 기관: 대량 샘플의 신속 검사
- 🧁 유제품/제과: 변질 위험이 큰 품목에 적합
100장, 1000장 단위의 대량 패키지로도 제공되어 검사량이 많은 산업군에 적합한 제품입니다.
결론 – “이제는 선택이 아닌 필수입니다”
식품 및 음료 산업에서 ‘품질’은 단순한 기술력이 아닌, 고객 신뢰와 브랜드 지속성을 의미합니다.이러한 신뢰의 출발점은 바로 미생물 안전 관리에서 시작되며, 그 중심에 효모 및 곰팡이 측정이 있습니다.Neogen의 Petrifilm® Yeast and Mold Count Plate는 단순한 실험 도구를 넘어,현장의 시간과 비용, 인력 리소스를 혁신적으로 절약해주는 고성능 품질관리 솔루션입니다.
기존 3M의 품질은 유지하면서, Neogen의 고객 중심 지원과 기술력을 더한 지금의 Petrifilm®은전보다 더 강력한 신뢰성과 편의성을 제공합니다. 이 제품은 단순히 “편리하다”에서 멈추지 않습니다.
- AOAC 인증으로 검증된 정확성
- 40년 이상 전 세계 산업 현장에서 축적된 신뢰
- 샘플 준비만으로 누구나 빠르게 사용할 수 있는 직관적인 설계
- 기존 실험실 공정을 최소화하여 시간과 비용의 효율까지 확보
이 모든 요소는 결국 하나의 결론으로 이어집니다.바로, Petrifilm® 플레이트는 더 이상 선택의 여지가 아닌, 필수 도구라는 점입니다.제품 하나로 미생물 분석의 정확성, 속도, 안정성, 신뢰도를 모두 잡고 싶다면?
이제는 고민하지 마세요.
Petrifilm®을 선택하는 순간, 여러분의 품질관리는 한 단계 더 도약합니다.
📌 지금 바로 도입하고,
🔬 제품의 신뢰성과 공정의 효율성을 동시에 경험해 보세요!
'실험실 기자재 - 미생물배지' 카테고리의 다른 글
| 피펫 스왑 플러스, 실험 샘플링부터 미생물 검사까지 한 번에! (7) | 2025.06.20 |
|---|---|
| 초보자도 쉽게! 페트리필름 EC 카운트 플레이트 해석하기 (0) | 2025.05.14 |
| 황색포도상구균, 24시간 내 판독하는 Staph Express의 모든 것 (0) | 2025.04.23 |
| 식품 내 세균 검사, MicroFast Bacillus Cereus Count Plate로 간편하게 (2) | 2025.04.20 |
| 리스테리아 검출 솔루션, Petrifilm EL Plate 사용법부터 분석법까지 한번에 (0) | 2025.04.19 |